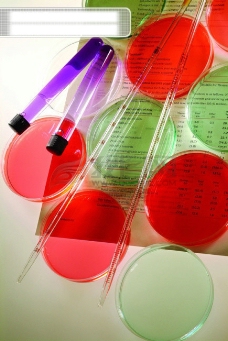
生化科技 试管 细胞组织液 微生物 人体

组织液图片

细胞外液是细胞生活的液体环境,主要包括血浆,组织液,淋巴.
图片尺寸640x334
有没有人用过人造胎盘组织液?效果怎么样?
图片尺寸576x768
macs tissue storage solution 组织保存液
图片尺寸3421x2389
macstissuestoragesolutionmacs组织存储液
图片尺寸1250x1250
组织液的生成与回流ppt
图片尺寸1080x810
03组织固定液5ml
图片尺寸600x600
(1)细胞浸浴在组织液中,两者之间只隔着细胞膜,水分和一切能够透过
图片尺寸981x735
组织液是什么东西
图片尺寸570x228
细胞组织液镜下结构图片
图片尺寸1200x800
雨露10%福尔马林中性固定液 组织标本固定液 病理组织保存液500ml
图片尺寸800x800
环兴牌人胎盘组织液让女性朋友美上加美解放军总医院神经内科退休专家
图片尺寸535x365
组织固定液(含醛型)
图片尺寸1080x1144
ams0001,4%多聚甲醛(通用型组织固定液),500ml
图片尺寸2835x2835
4%组织细胞固定液 - 迈基生物
图片尺寸991x1212
组织固定液b型
图片尺寸800x800
体液,比较脏.有些患者自己都受不了.捏着鼻子送标本.
图片尺寸2667x2000
生化科技 试管 细胞组织液 微生物 人体
图片尺寸228x341
内环境(又称体液环境),我们人体重量的50-70%是水分,包括血液,组织液
图片尺寸707x543
10%中性福尔马林固定液病理组织甲醛标本保存38%养殖水产消毒溶液
图片尺寸800x800
高效ripa裂解液(组织/细胞)
图片尺寸2976x2976